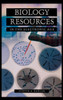

How can students, teachers, parents, and librarians be certain that the information a Web site provides is accurate and age appropriate? In this unique book, experienced science educator Judith A. Bazler reviews hundreds of the most reliable biology-related Web sites. Each review discusses the most appropriate grade level of the site, analyzes its accuracy and usefulness, and provides helpful hints for getting the most out of the resource.
The Web is the first place many students look for information. Yet the Web is notoriously unreliable. How can students, teachers, parents, and librarians be certain that the information a Web site provides is accurate and age appropriate? In this unique book, experienced science educator Judith A. Bazler reviews hundreds of the most reliable biology-related Web sites. Each review discusses the most appropriate grade level of the site, analyzes its accuracy and usefulness, and provides helpful hints for getting the most out of the resource. Sites are organized by topic, from Adaptation to Viruses, making it easy to locate the most useful sites. A handy summary presents the best places on the Web to find information on science museums, science centers, careers in biology, and biology supplies.| Author: Judith Bazler |
| Publisher: Greenwood |
| Publication Date: Sep 30, 2003 |
| Number of Pages: 304 pages |
| Binding: Hardback or Cased Book |
| ISBN-10: 1573563803 |
| ISBN-13: 9781573563802 |